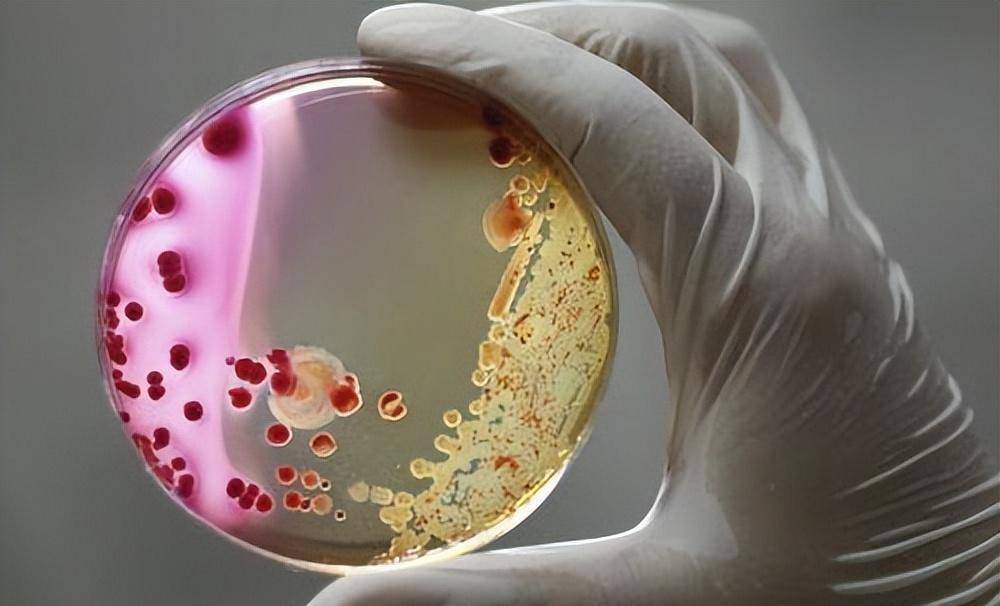

2000年,吉林19岁女孩被奸杀,警察凭一个脱落细胞20年后抓获真凶
原标题:2000年,吉林19岁女孩被奸杀,警察凭一个脱落细胞20年后抓获真凶
都说“父母是孩子的第一任老师”!一个良好的家庭环境,对子女身心健康的塑造,起着至关重要的作用。
在吉林白城,有一个青年小伙长期遭受父母暴力虐待,造成了心理扭曲、人格缺陷。终于在他21岁那年,因为终身大事问题,多年来积累的怨念爆发,在失去理智下,奸了邻村一名19岁的女孩。
受害女孩的父母不堪打击,3年内先后病逝。青年小伙畏罪潜逃,结婚生子,但因为过去的经历和放不下的往事,导致2个女儿的人生也叛逆被毁。
一桩惨案,改变了两个家庭,毁去了三代人!更加让人觉得不可思议的是,警察单凭当年的一个脱落细胞,在20年后将真凶成功擒获。

19岁女孩被奸,凶手无法确认
2000年8月24日中午,在吉林省洮南市聚宝乡,村民王世友和妻子张少侠吃过午饭后,开着三轮农用车去地里干活。
当路过一片郁郁葱葱的玉米地时,王世友瞥了一眼左边的地沟,却发现了无比震惊的一幕:
一个年轻女孩浑身是血的躺在玉米地沟里,一动不动,看样子是出了大事!
受到惊吓的王世友立马调转车头,妻子不明所以,开口询问,王世友用手指了指玉米地沟,张少侠看了两眼后,立马认出了那是邻村老祝家的二姑娘。
慌乱的夫妻俩立刻跑回村庄,赶到村委会向村长报告,村长听完后立刻拨打了报警电话,不一会儿,公安局刑警队就赶到了案发现场。
经过警方确认,玉米地沟的年轻女孩已经遇害,尸体的左胸部位有刀伤,由此造成心脏破裂亡。
在法医对尸体进行详细检查后,确认女孩在生前有被人侵害的迹象!

案件的质如此恶劣,警方首先对者的身份进行了确认,正如张少侠所说,那的确是老祝家的二姑娘——祝某红。
原来,老祝家在苇塘村,与王世友所在的村庄相邻。他家里种有几棵沙果树和几块地的蔬菜,每年到了果实成熟的季节,祝某红便会跟着姐姐一起去街上卖菜,一来二去,附近的村民都认识了老祝家的2个女儿。
可是在案发的一年前,大女儿因病不幸离开人世,从此祝某红形单影只,只好一个人独自上街卖沙果、卖菜。
平时祝某红早上离家,中午会回家吃午饭,这次老祝夫妇等了很久也没有见女儿归来。考虑到今天或许东西不好卖,女儿会多耽搁一会,夫妻俩也就没有多想。
可是半下午的时候,警方来到家里让夫妻俩人去辨认尸体,二人这才知道,自己19岁的女儿在回家途中被人奸了。
极度的痛苦和愤怒涌上夫妻二人的心头,女儿刚刚成年,还没有嫁人生子,到底是谁做出这么丧尽天良的事呢?
当警方对现场仔细勘察后,却没有发现任何与嫌疑人有关的痕迹,也没有找到作案凶器。
因为案发是在中午时分,又是靠近一条农田小道,那会不会有目击者呢?可警察对周围民众进行走访调查后,并没有发现有人目睹了案发经过。

毫无线索让案件的侦破陷入了僵局,既然没有直接证据,那就只有通过现场来进行推断排查了。
因为案发现场比较闭塞,周围都是玉米地和农间小道,离公路比较远,所以本地耕种劳作人员作案嫌疑比较大。
被害人前受过侵犯,被利刃刺破心脏而亡,由此警方推断,凶手是18至45岁之间,随身携带刀具的青壮年男。
在对一些具有前科劣迹和爱带刀的青年男进行排查后,警方梳理出了七八个重点嫌疑人员。可细致调查后,他们要么是没有作案时间,要么不具备作案条件,最后都一一排除了。
没有找到凶手,不甘心的警方又将案发地点周边几个村所有适龄的男青年全都划入排查范围之内,用几个月时间挨家挨户逐一确认信息,结果仍旧是一无所获。
在痕迹专家的努力下,通过对现场的反复勘验,虽然没有找到血液、指纹等生物检材,但经过反复擦拭,最终提取到了一个脱落细胞。
这是这件凶案最后的、也是唯一一点线索!
所谓“脱落细胞”,是指人体自然管腔器官内表面粘膜的正常脱落。可在当时那个年代,技术条件有限,脱落细胞不像指纹、血液检测那样直观,警方无法从上面提取到DNA,以此来比对嫌疑人。
女孩父母3年内病逝,20年后案子峰回路转
案件无奈被搁置后,参与办案的刑警非常沮丧,而更让他们感到痛心和惋惜的是,被害人祝某红一家的命运。
祝家夫妇只有两个女儿,没有儿子。在案发一年前,大女儿因病去世后,夫妻俩内心无比伤痛。
正当他们逐渐走出阴影,将所有的爱给予小女儿祝某红时,没想到小女儿在玉米地沟里。
祝某红原本是一个很懂事的孩子,她勤劳善良,街坊邻居看到了都夸她,每天起早贪黑帮父母干活卖菜,成为了老两口余生的依靠。
接连的打击让祝家夫妇无法承受,而凶手迟迟没有归案,无法还小女儿一个公道,更是让他们心中忧愤难平。短短3年时间内,祝家夫妇相继病倒,郁郁而终!
好好的一个家,就这样被彻底毁灭了,这可真是人间惨剧,老两口没有看到凶手被绳之以法,定然也会不瞑目。
警方肩上的压力十分巨大,但因为缺乏线索,连嫌疑人是谁都不知道,他们虽然几次揭开此案重新调查,可始终都是无从下手。
祝中午是被害人祝某红的叔叔,在哥哥嫂子离世后,便由她来为侄女讨还公道。
在面对记者的采访时,祝中午曾眼含热泪地说道:
“小红的冤枉,我大哥一家也太惨了,我们没有一天不希望早日抓到凶手!可什么都没有,该怎么查呢?头十年还有一点希望,我也经常去公安局询问,可时间久了,还是没有眉目,或许真相永远无法解开……”

转眼间20年过去了,2020年,国家公安部颁布了“云剑行动”,提出要对命案积案进行攻坚。在号召之下,洮南警方重新启动了对祝某红案的研判。
20年的时光早已是物是人非,可随着DNA检验技术的发展,当年那个起不了作用的脱落细胞,如今已经可以通过技术手段,从上面提取到DNA了。
因为案件资料积累太过庞杂,在警方翻了6000多份的物证后,终于在资料架最底部的一个发黄物证袋里,找到了当年封存好的那个脱落细胞。
经过技术人员几天的努力提取,一个振奋人心的消息传来,犯罪嫌疑人的DNA被成功找到。
在系统数据库中,这份DNA没有被成功比中,警方研判之后,坚持当年的判断,嫌疑人应该就是案发地附近的村民。
时过境迁,当年案发地的很多村民都已经搬迁,有的去了外省打工,有的人也已经过世不在。
警方不遗余力,顺着线索进行走访摸排,落实到十余个县市,终于将DNA与其中的一个人比中。
对方名叫冯某勇,当年就住在洮南市的聚宝乡,家离案发现场不到一公里的距离。从时空轨迹来看,冯某勇有重大的作案嫌疑。
进一步调查之后,得知冯某勇正在河北的霸州打工,于是警方立马出击抓捕,冯某勇束手就擒,承认了犯罪事实,并交代了全部过程。

父母长期暴力,是冯某勇犯罪的根源
冯某勇被抓时,并没有表现出强烈的反抗,而是一副如释重负的样子,似乎早知道这一天会来临。
多年来,自己的犯罪事实压在心里,冯某勇整天也是生活在惶恐之中,不堪重负,如今警察找上门来,他觉得这是一种解脱和自由。
悬了20年的案子终于告破,警方们如释重负,将凶手告知了祝某红的亲属。
可当得知案子是冯某勇干的时,村民们全都惊讶万分,他们直呼不可能,根本不敢相信冯某勇会是20年前的凶手。
“他老实巴交的,不爱出去,也不咋吱声,跟一般人也不来往。”
“挺好的一个人,从来没跟别人干过仗(打架),很沉稳。”
“心理上没承认他干的!感觉很不可能,真的很震惊……”
在村民和邻居的口中,冯某勇就是一个老实善良的人,如此穷凶极恶、丧尽天良的事,怎么会是他做的呢?
面对众人的疑惑,冯某勇虽然很痛苦挣扎,但还是说出了背后所隐藏的一切。只是人们在听完之后,很是唏嘘和感慨!

一切都得从冯某勇原生态家庭开始说起!
冯某勇出生于一个五口之家,父母生有三个孩子,在三兄妹中,他排行老二。
在外人看来,这个家庭十分普通平常,可在冯某勇的心里,家就像是一个噩梦,一直缠绕伤害着自己。
原来,冯某勇的父亲有严重的家庭暴力,他让冯某勇干什么,冯某勇就得去,稍微有点不顺心或者儿子犯点小错误,冯父就会对他一顿毒打,笤帚杆子经常打断,夜里睡觉只能趴着。
都说严父慈母,可冯某勇的母亲也是一样,也会经常对儿子使用暴力,只不过没丈夫打得那样凶狠。
生活在这样一个家庭中,别说亲情的温暖,很多时候连温饱都没有。几天不给吃饭,上外面对墙壁跪着,这些折磨虐待,冯某勇饱尝了千百遍。
更让冯某勇不理解、心里不平衡的是,父母的虐待只针对他一个人,自己有一个哥哥和一个妹妹,他们二人都很受父母的宠爱。
有什么好吃的,母亲总是留给哥哥,哥哥想买玩具买东西,父亲会给个三五块,而自己想买一个文具,父亲连五钱都舍不得花。
两个儿子在父母的那儿是两种截然不同的态度,在他们眼里,大儿子错也是对,冯某勇对也是错!
然而,冯某勇的哥哥也没有拥有光明的人生,在父母的百般宠溺下,成年后的他因犯罪,被司法机关判刑。

因为父母的暴力虐待和偏心对待,冯某勇内心的暴力因子不断滋生成长,在家庭的压制之下,冯某勇一直将其隐藏在内心深处,不敢发作出来。
就这样长到了20岁,辍学已久的冯某勇到了谈婚论嫁的年龄,他看上了邻村的一位美丽的姑娘,两人十分聊得来,对未来的生活共同充满了向往。
可是因为家庭暴力的原因,冯某勇不敢对父母说,只能私下和那名姑娘交往。
一年后,村里人给冯某勇的父母介绍了另外一名随姓姑娘,她小学还没念完,以放羊为生,干农活十分娴熟有力。
冯某勇的父母一下子就看中了这位姑娘,他们没有征求冯某勇的意见,直接将亲事定了下来,准备择吉日让两人完婚。
连自己的婚姻大事都无法做主,这让冯某勇难以接受,一腔怒火压在心里,勾引起了内心暴力仇恨的种子。
极度压抑之下,2000年8月24日,冯某勇一个人走在田间小路上,想到多年来在家里面受到种种不公平的待遇,他的情绪逐渐失控了。
就在这时,卖完沙果的祝某红准备回家吃午饭,见四周无人,21岁的冯某勇的内心产生了罪恶的念头。他肆无忌惮地发泄着心中的不满和怒气,借着玉米杆的掩盖,在地沟里将祝某红给奸了。

三代人的不幸,2个女儿也被毁
人后的冯某勇瞬间清醒,他慌忙回到家中,假装什么事情都没有发生,也没有将此事告诉给任何人。
那段时间,警察挨家挨户排查,警车每天都在眼前转悠,冯某勇的心里极度恐惧,只能在家里窝着,尽量不引起他人的注意。
因为缺乏线索,警方最终没能怀疑到他的头上。风声稍微平静一点后,冯某勇只能听从父母的话,跟随姓女子结婚,两人一起在家里种地。
3年后,当听说祝家夫妇因为悲痛含恨而亡时,冯某勇的心里深深自责。自己因为冲动泄愤,导致好好一个家庭家破人亡,每晚睡觉时,他都辗转反侧,噩梦缠身。
后来,冯某勇带着妻儿去了河北霸州打工,以此来远离自己的故乡,逃避内心深处的梦魇。
虽然冯某勇早已长大成人,父母也不再对他虐待责罚,可因为过去的经历深深印在心里,导致他在教育自己孩子时,也十分的严厉和极端。
一方面让他痛恨父母的暴力,而又因为长期受这种教育方式的影响,导致他在遇到问题时不知道该怎样教育孩子,只能通过打骂来强行压制。

冯某勇有一个儿子、两个女儿,在对女儿的管束方面,比对儿子要严苛很多。
之所以对女儿如此严格,那是因为当年他奸祝某红时,祝某红临前那绝望痛苦的样子,深深刺激到了冯某勇。他害怕女儿在交朋友时,也会遇到像他一样的坏人,从而遭遇不测。
父亲本身就是一个恶魔,却担心自己的女儿会遇到其他恶魔,这怎么看都觉得是一种莫大的讽刺!
家庭暴力和不明缘由的严苛,最终让冯某勇的女儿无法理解接受,这也让她们的人生叛逆被毁。
在大女儿17岁时,她一个人离家出走去了杭州,两年来杳无音讯,冯某勇和妻子联系不上她,也不知道她最近的状况怎样。
小女儿虽然刚上高中,但学习成绩很差,经常和社会上的一些人混在一起,甚至染上了抽烟酗酒的坏病,父母说她两句,她就会消失几天几夜不归家。
两个女儿如此叛逆,大好青春年华缺乏正确的人去引导,未来会怎样,我们不敢往下深想。
冯某勇人,这是法律上的重罪,即使没有判处刑,无期徒刑或长期的有期徒刑那是在所难免。
这便是冲动之下违反法律的代价!

结语
祝某红遭害、祝家夫妇含恨而亡、冯某勇被抓入狱、冯某勇的两个女儿叛逆被毁,两个家庭、三代人的不幸,正是冯某勇那一次错误发泄心中情绪造成的。
而究其根源,冯某勇内心深处暴力仇恨的种子,是父母的虐待和偏心在日复一日的积累下才开花结果。
所以,父母是孩子的第一任老师!在家庭教育方面,要做到刚柔相济、宽严有度,不能过分宠溺,也不能过分严苛。
法律是不可逾越的底线,任何违反法律的犯罪行为必然会受到相应的惩处。虽然时过20年,但天网恢恢、疏而不漏,警察最终凭借一个脱落细胞抓获真凶,还了受害者及其亲属一个公道。
希望大家有所启示,引以为戒……
【文/若木图/网络】
(关注
@若木小刀